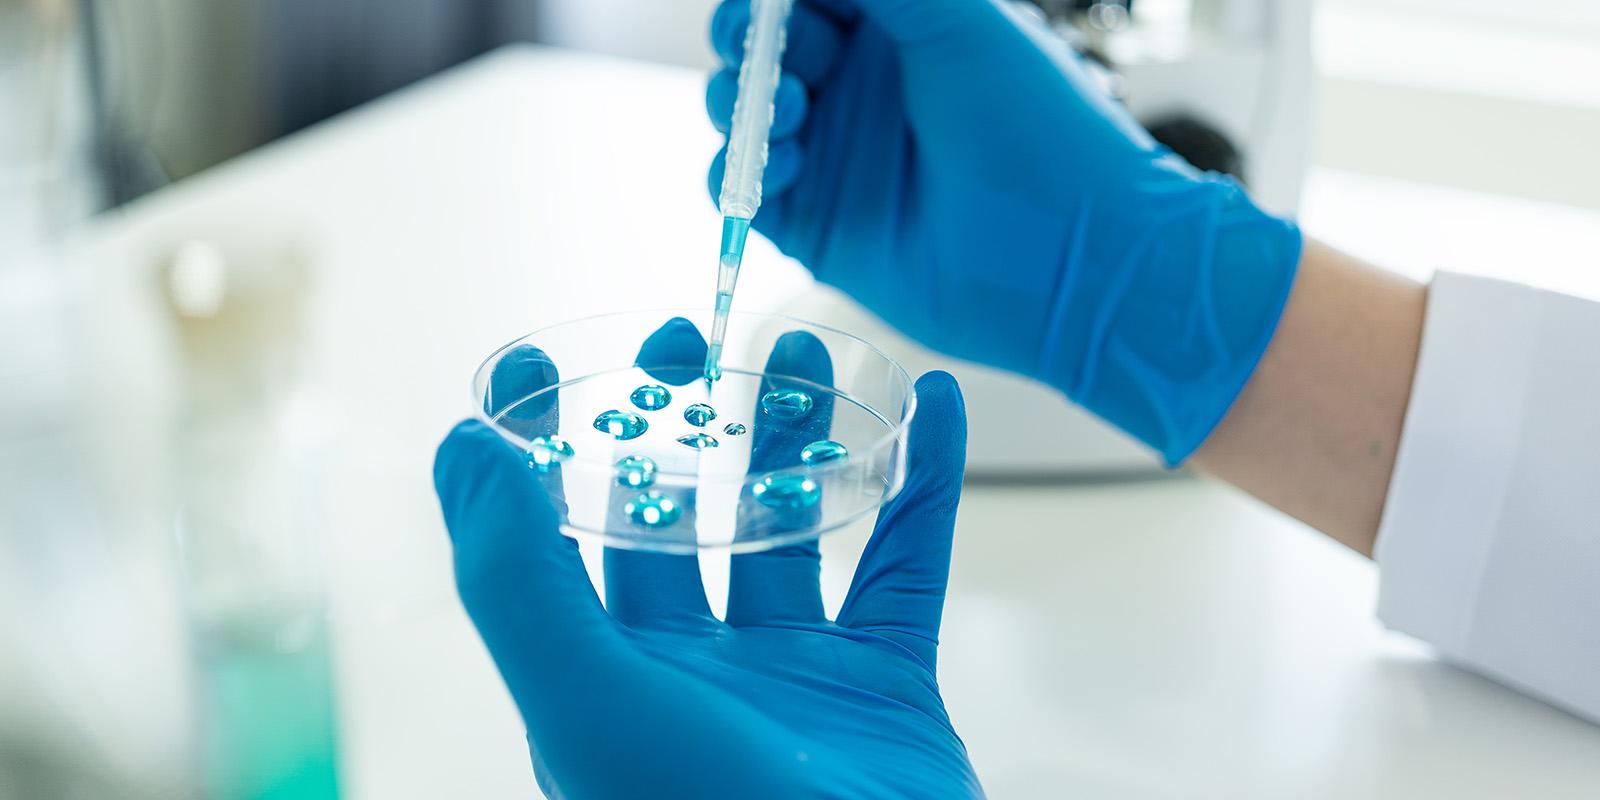

Mintz advised Wave Life Sciences in its $402.5 million public offering.
Jefferies, Leerink Partners, and BofA Securities were the joint book-running managers for the offering. Truist Securities and Mizuho were book-runners.
The Mintz capital markets team included William Hicks, John Rudy, Nishant Dharia, Alok Choksi, Samantha Silver, Gianna Nappi, Gretchen Goyette, and Patricia Garza Gonzalez. Gregg Benson and Liz Allison advised on tax matters.
Members of the Mintz team are based in the Boston, New York and San Diego offices.










